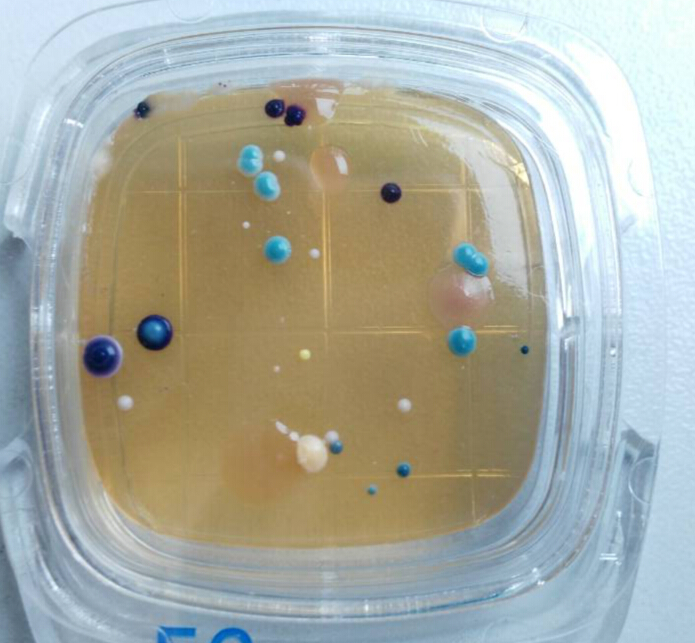

檢測認證人脈交流通訊錄
檢測認證人脈交流通訊錄
- 接觸性瓊脂培養基
接觸性瓊脂培養基
性能特點
1.廣泛適用于環境衛生、工器具、空氣塵埃及手的菌檢查。
2.開封后直接使用,無需配置培養基,省時、省力!
3.培養基面積10㎡,并分10個小格,計數方便。
AC.標準平板計數瓊脂培養基
用于細菌總數的測定
EC.三色瓊脂培養基
大腸桿菌、大腸菌群同時檢測。
E.coli菌落呈藍色-淺紫色。
大腸菌群菌落呈紅色-紫色。
其它腸道菌菌落呈乳白色。
SA.金黃色葡萄球菌瓊脂培養基
金黃色葡萄球菌在培養基表面形成黑色菌落,并且由于蛋白分解,金黃色葡萄球菌菌落周圍會形成透明溶血環或渾濁帶。
PD.酵母菌、霉菌的測定。
使 用 方 法
黄色网址在线免费看|
400部精品国偷自产在线观看|
色婷婷.com|
欧美一级片黄色|
做a视频在线观看|
一区二区视频观看|
国产极品在线播放|
免费看特级毛片|
亚洲av无码精品一区二区|
欧美另类videoxo高潮|
看黄色一级大片|
男女裸体影院高潮|
亚洲精品一区二区三区不卡|
日本xxxxxxx免费视频|
逼特逼视频在线观看|
欧美人妻精品一区二区免费看|
麻豆精品免费视频|
国产午夜麻豆影院在线观看|
无码毛片aaa在线|
www香蕉视频|
五月婷婷丁香综合网|
黄色在线观看av|
久久久国产精品成人免费|
老司机av福利|
欧美在线 | 亚洲|
中文字幕1234区|
国产视频精品免费|
亚洲国产视频一区二区三区|
少妇网站在线观看|
97精品在线播放|
www.日韩在线观看|
永久av免费在线观看|
777777国产7777777|
亚洲欧美黄色片|
中文字幕在线视频一区二区|
中国毛片直接看|
亚洲av无码国产精品久久不卡|
一区二区xxx|
日本少妇高清视频|
天天爽夜夜爽视频|
国产成人愉拍精品久久|
国产一区二区三区在线免费|
最新国产精品自拍|
亚洲男人天堂网址|
免费黄色一级网站|
天天鲁一鲁摸一摸爽一爽|
欧美一级特黄aaaaaa|
国产大片aaa|
欧美 日韩 激情|
1024手机在线观看你懂的|
国产同性人妖ts口直男|
一级黄色大片儿|
久艹在线免费观看|
亚洲av无码国产精品麻豆天美|
怡春院在线视频|
欧美日韩久久婷婷|
欧美精品久久久久久久自慰|
国产美女免费网站|
亚洲精品综合久久|
日本一本在线观看|
欧美国产精品一二三|
日韩视频免费播放|
国产福利视频网站|
亚洲色偷偷色噜噜狠狠99网|
国产精品久久久久久久免费看
|
日本黄色a视频|
日本不卡视频一区|
www.日韩高清|
欧美成人一区二区三区四区|
中文字幕亚洲影院|
国产精品沙发午睡系列|
色婷婷在线视频观看|
自拍视频一区二区|
午夜国产在线视频|
97人妻精品一区二区三区动漫|
国产无遮挡又黄又爽在线观看|
天天摸天天碰天天添|
97超碰人人爱|
99久久精品久久亚洲精品|
成人性生活免费看|
亚洲欧洲视频在线观看|
国产剧情久久久|
久久久久久亚洲av无码专区|
欧美成人手机视频|
国产女同无遮挡互慰高潮91|
18禁男女爽爽爽午夜网站免费|
久久久久久久久久网站|
黄色av片三级三级三级免费看|
黄色激情在线观看|
一级全黄裸体片|
欧美自拍偷拍第一页|
www.99视频|
国产成人精品毛片|
国产免费一区二区三区最新不卡|
亚洲永久精品一区|
日韩精品久久久久久免费|
久久久全国免费视频|
伊人成人免费视频|
一级黄色录像在线观看|
制服丝袜综合网|
午夜宅男在线视频|
日本 片 成人 在线|
亚洲三级视频网站|
亚洲欧洲日本精品|
可以看污的网站|
天天摸天天舔天天操|
手机免费看av网站|
91香蕉视频免费看|
国产精品自拍视频一区|
日本a在线观看|
欧美激情亚洲综合|
亚洲av无码不卡|
夜夜躁很很躁日日躁麻豆|
在线视频你懂得|
国产视频在线观看视频|
xxxwww在线观看|
免费成人在线看|
日本女人性视频|
亚洲天堂av网站|
少妇毛片一区二区三区|
亚洲色成人网站www永久四虎|
美女100%露胸无遮挡|
久久精品一区二区三区四区五区|
久久久久亚洲AV成人|
草草草视频在线观看|
高清欧美精品xxxxx|
三级4级全黄60分钟|
羞羞的视频在线|
国产精品7777|
正在播放亚洲精品|
黑人精品一区二区三区|
亚洲美女精品视频|
免费看黄色av|
a级黄色片网站|
国产特级淫片高清视频|
8x8x最新地址|
国产精品久久久免费视频|
欧美成人一区二区视频|
空姐吹箫视频大全|
www.超碰97|
免费观看中文字幕|
国产精品亚洲a|
国产精品7777|
国产草草影院ccyycom|
97超碰免费在线观看|
色屁屁草草影院ccyy.com|
天天干天天操天天干天天操|
99爱视频在线|
久久午夜鲁丝片午夜精品|
中文在线最新版天堂|
香蕉视频成人在线|
成人一级片免费看|
国产精品亚洲αv天堂无码|
亚洲热在线视频|
国产精品一区二区三区在线免费观看|
亚洲 欧美 激情 小说 另类|
91社区视频在线观看|
91精品国产91久久久久麻豆 主演|
三级视频中文字幕|
69国产精品视频免费观看|
欧美特级特黄aaaaaa在线看|
免费毛片视频网站|
人妻少妇精品无码专区二区|
黄色a级三级三级三级|
国产伦理吴梦梦伦理|
国产精品无码一区二区三|
视色,视色影院,视色影库,视色网
日韩精品福利片午夜免费观看
|
欧美a级免费视频|
午夜天堂在线视频|
一区二区的视频|
国产熟妇搡bbbb搡bbbb|
日本一区午夜艳熟免费|
五月天婷婷网站|
熟妇高潮一区二区高潮|
91插插插插插插|
91pony九色|
亚洲av永久无码国产精品久久
|
久久国产精品影院|
97国产在线播放|
精品无码一区二区三区的天堂|
涩视频在线观看|
国产乱淫av片杨贵妃|
日产精品久久久久久久|
伊人久久久久久久久|
成人高清dvd|
国产乱国产乱老熟|
亚洲久久久久久|
日韩av资源在线|
中文字幕在线播放不卡|
av手机在线播放|
久久人人爽av|
天天干天天草天天射|
日韩在线视频在线|
亚洲欧美另类在线视频|
黄瓜视频污在线观看|
国产免费999|
内射后入在线观看一区|
91亚洲精品国产|
69亚洲精品久久久蜜桃小说|
五月天综合视频|
亚洲综合123|
折磨小男生性器羞耻的故事|
六月激情综合网|
肥臀熟女一区二区三区|
久久久久久久久久久综合|
日本熟妇一区二区三区|
美女av免费看|
香蕉免费毛片视频|
免费人成又黄又爽又色|
欧美日韩亚洲国产另类|
极品白嫩的小少妇|
国产精品视频分类|
成人三级做爰av|
一区二区三区韩国|
五月天激情婷婷|
熟妇人妻va精品中文字幕
|
久久黄色一级视频|
日本三级免费观看|
免费国产黄色片|
浮妇高潮喷白浆视频|
成人免费一级视频|
麻豆av免费在线|
手机看片福利在线|
国产精品视频黄色|
成人啪啪18免费游戏链接|
亚洲77777|
91av在线免费|
久久中文字幕在线观看|
中文字幕在线看高清电影|
国产一级视频在线|
久久久国产一级片|
欧美brazzers|
91精品一区二区三区四区|
国产又粗又大又黄|
日本欧美黄色片|
性感美女福利视频|
久久久精品高清|
亚洲国产日韩一区无码精品久久久|
www.99re7.com|
在线观看黄网址|
一区二区三区www污污污网站|
成年人网站国产|
日韩一级片免费看|
久久久久久综合网|
午夜激情视频在线播放|
91丨porny丨在线中文
|
国产女主播喷水高潮网红在线|
久久综合成人网|
免费在线黄色网|
丰满人妻一区二区三区免费|
一路向西2在线观看|
少妇无套高潮一二三区|
最近日韩免费视频|
黄色片视频在线免费观看|
精品影片一区二区入口|
亚洲日本韩国在线|
少妇大叫太大太粗太爽了a片小说|
丰满人妻一区二区三区免费视频|
8x8x最新地址|
国产极品视频在线观看|
国产乱淫a∨片免费视频|
日韩精品一区二区三区不卡|
国产又粗又猛又爽视频|
一级日韩一级欧美|
中文字幕av不卡在线|
战狼4完整免费观看在线播放版|
国产精品伊人久久
|
国产精品一色哟哟|
亚洲av人人澡人人爽人人夜夜|
91av在线免费视频|
欧美爱爱视频免费看|
日韩精品电影一区二区|
国产又粗又黄又爽|
福利视频999|
亚洲av首页在线|
北岛玲一区二区|
国产免费黄色大片|
欧美成人精品一区二区免费看片|
国产大尺度在线观看|
中文字幕在线视频播放|
亚洲精品一区二区二区|
伊人影院综合在线|
300部国产真实乱|
97超碰在线免费观看|
国产同性人妖ts口直男|
久久久精品视频免费|
中国丰满人妻videoshd|
91社区视频在线观看|
亚洲欧洲国产综合|
日韩久久久久久久久久|
亚洲综合20p|
久久久性生活视频|
国产老头老太做爰视频|
亚洲av无码成人精品区|
一区二区日韩视频|
国产成人亚洲欧洲在线|
日本久久精品一区二区|
99久热在线精品视频|
免费看污片网站|
wwwxxx色|
国产成人精品无码高潮|
69国产精品视频免费观看|
四季av一区二区三区|
自拍日韩亚洲一区在线|
欧美亚洲日本在线|
亚洲一级中文字幕|
性一交一黄一片|
亚洲风情第一页|
中文字幕免费播放|
亚洲 欧美 日韩 综合|
国产喷水theporn|
69堂免费视频|
男女日批视频在线观看|
麻豆精品国产免费|
91成人在线免费视频|
久草免费资源站|
性感美女福利视频|
性生活三级视频|
亚洲天堂一二三|
国产情侣呻吟对白高潮|
99精品视频99|
国产一级做a爰片在线看免费|
日本激情综合网|
国产男女在线观看|
成人免费毛片网|
给我免费播放片在线观看|
三级在线免费观看|
av动漫免费观看|
97成人资源站|
免费高清在线观看电视|
国产在线观看免费视频软件|
欧美性受xxxx黑人|
jizz日本在线播放|
综合 欧美 亚洲日本|
久久久久久久久福利|
日本一级免费视频|
日本性高潮视频|
9.1片黄在线观看|
337人体粉嫩噜噜噜|
丁香花五月婷婷|
五月天免费网站|
欧美性生给视频|
日本爱爱小视频|
一级一片免费播放|
男人天堂成人网|
欧美无砖专区免费|
欧美变态另类刺激|
国产精品第12页|
一区二区免费av|
欧美极品视频在线观看|
久久综合色综合|
伊人中文字幕在线观看|
国产精品露脸视频|
国产精品久久久久久久免费看
|
中国a一片一级一片|
91精品在线视频观看|
国内精品久久久久久久久久久|
国产浮力第一页|
色欲av永久无码精品无码蜜桃|
亚洲色图另类小说|
国产精品jizz|
一级片一级片一级片|
www.国产亚洲|
国产精品无码专区av在线播放|
国产 porn|
99免费在线观看|
中文字幕观看视频|
成人午夜免费在线观看|
中文字幕天堂网|
男人天堂资源网|
激情成人开心网|
一区二区三区免费播放|
国产在线观看成人|
中文字幕欧美人妻精品|
十八禁一区二区三区|
中文在线一区二区三区|
日本 欧美 国产|
koreanbj精品视频一区|
日韩成人av免费|
日韩免费av网站|
少妇人妻精品一区二区三区|
成年人在线观看av|
99视频精品全部免费看|
午夜在线观看av|
亚洲精品男人的天堂|
精品黑人一区二区三区国语馆|
一个人看的视频www|
成人一级片免费看|
国产原创中文在线观看|
久久久久噜噜噜亚洲熟女综合|
中国黄色一级视频|
成人在线电影网站|
国产高潮呻吟久久久|
91小视频网站|
在线免费av网|
中文字幕日韩三级片|
波多野结衣与黑人|
精产国品一二三区|
国产成年妇视频|
欧美精品日韩在线|
 檢測認證人脈交流通訊錄
檢測認證人脈交流通訊錄